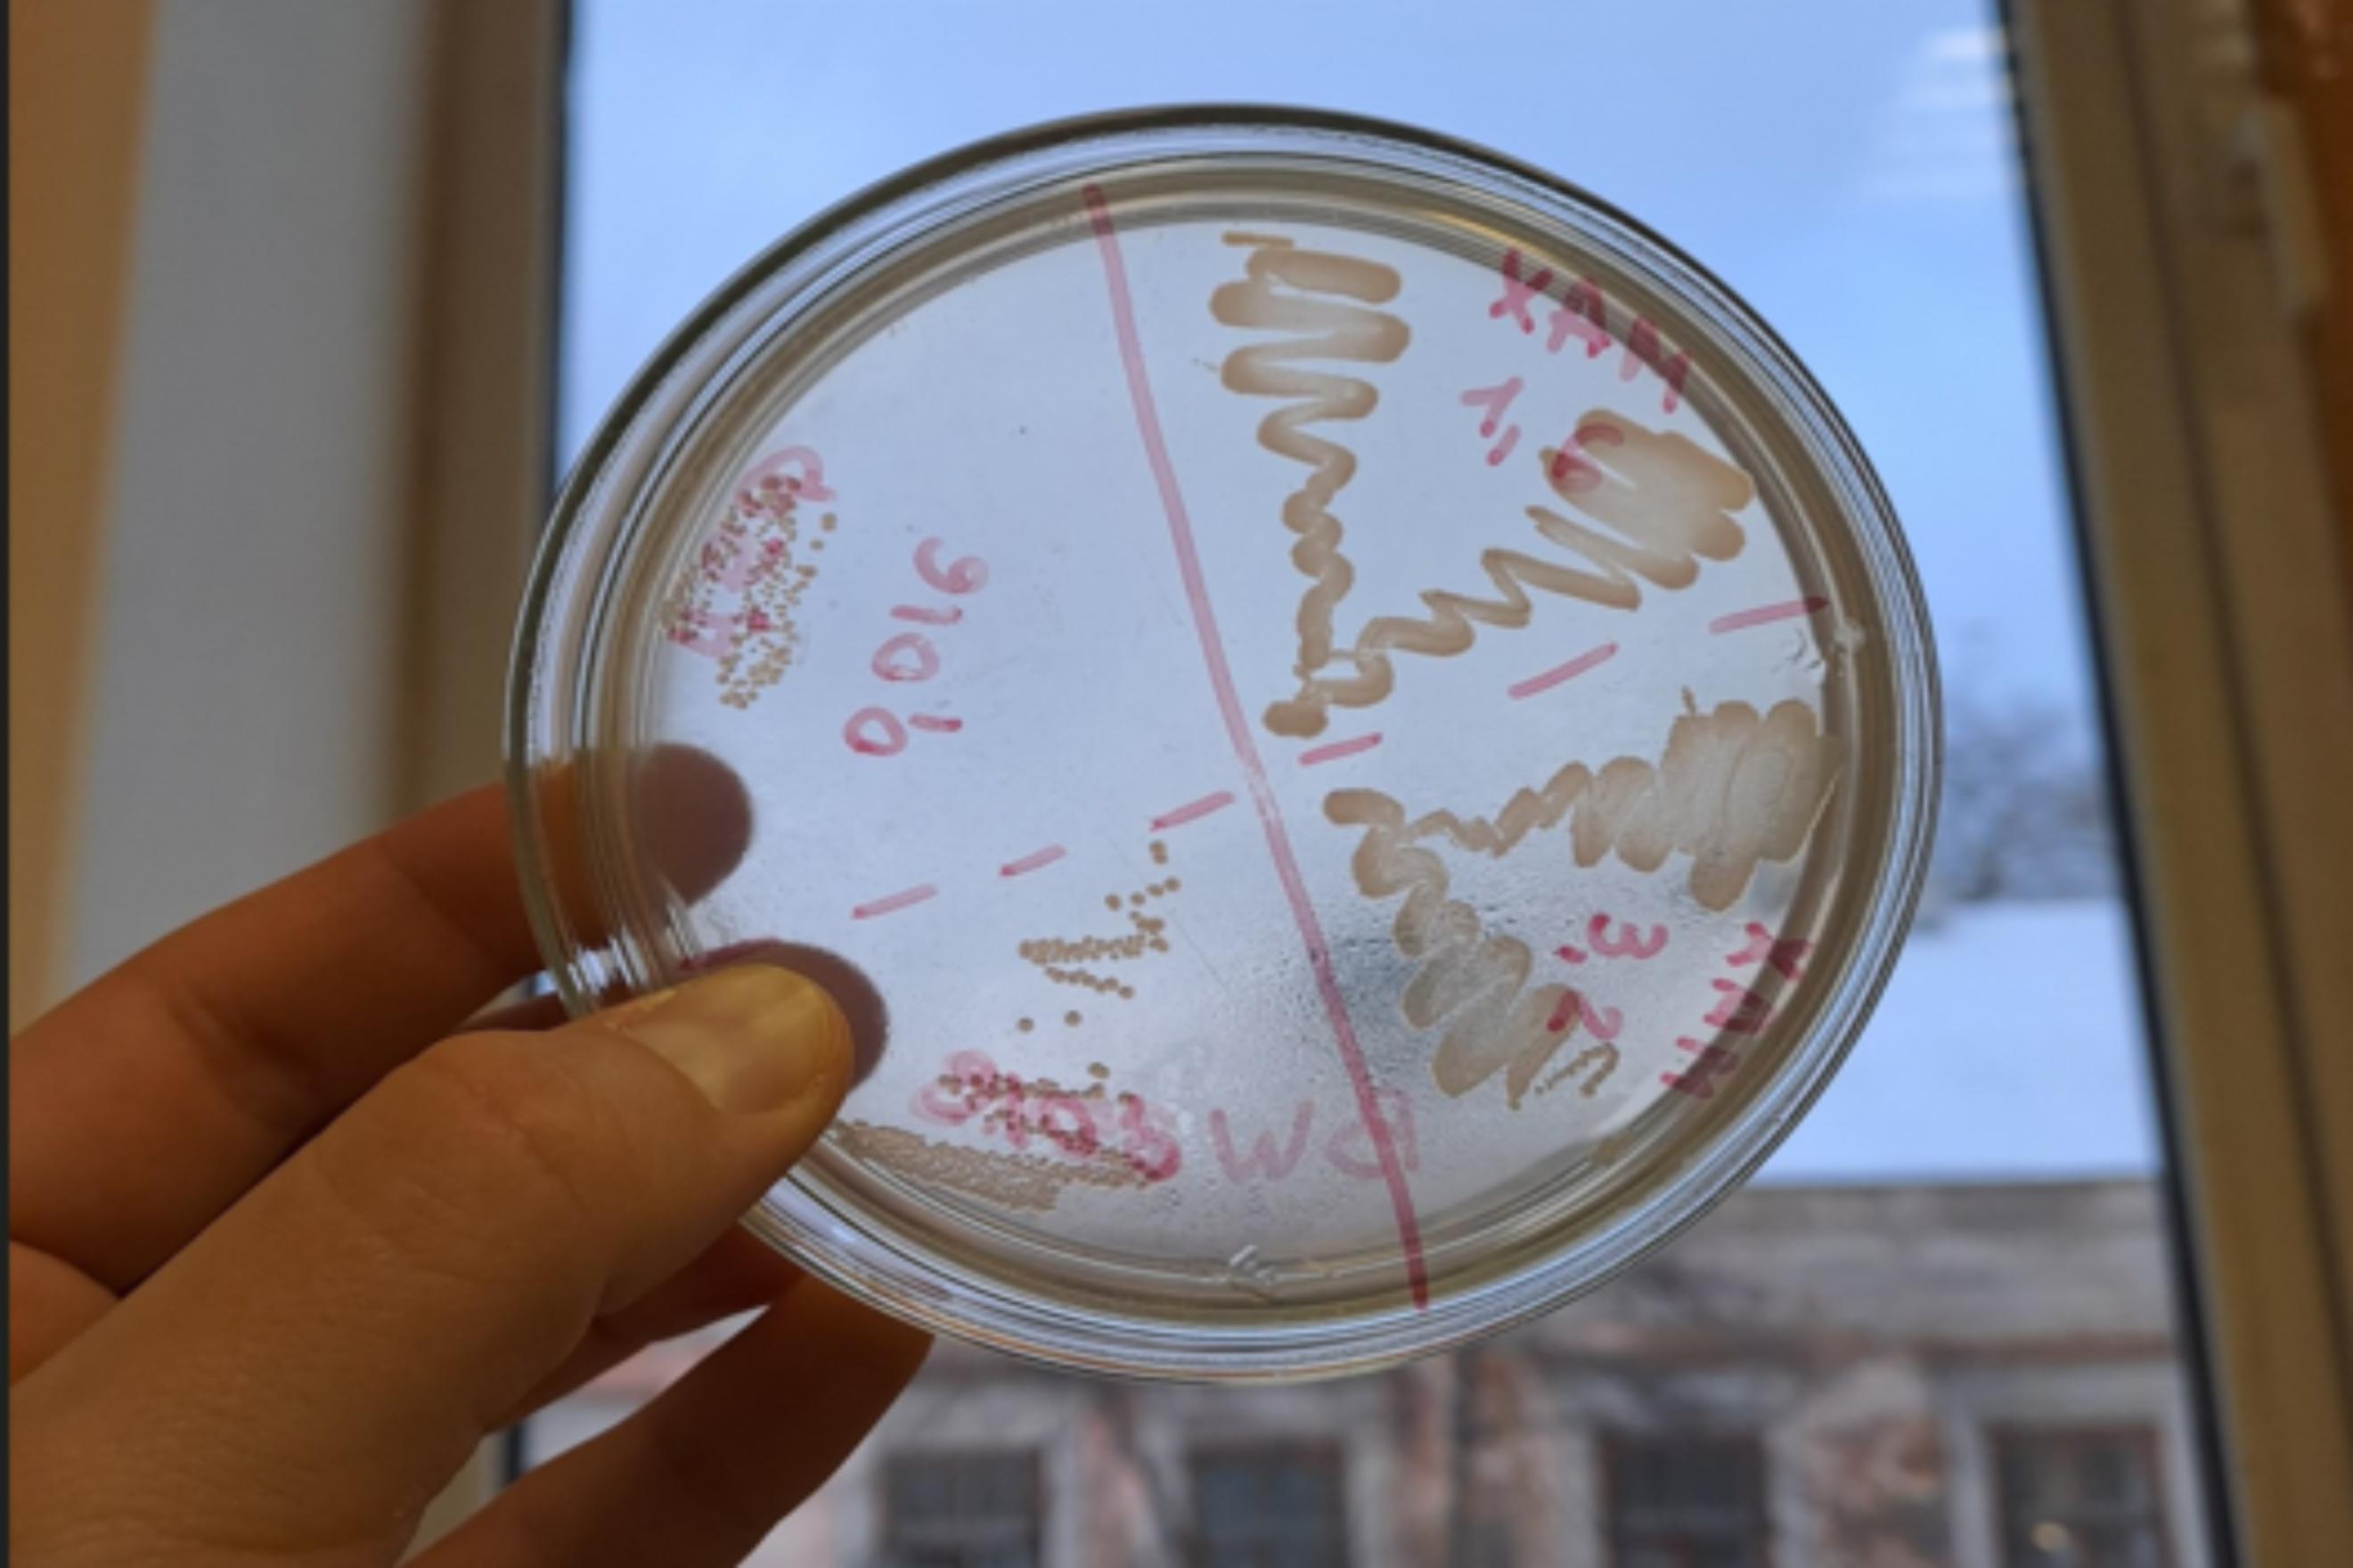

Как возбудители туберкулеза защищаются от антибиотиков
 24 марта — Всемирный день борьбы с туберкулезом. Болезнь остается одной из главных причин смерти от инфекций: каждый день от нее умирает больше 3500 человек, а заболевает около 30 тысяч. Ситуацию усугубляет антибиотикорезистентность: бактерии уже не реагируют на самые сильные препараты и мутируют быстрее, чем создаются новые. Ученые Пермского Политеха и УрО РАН выяснили, как именно возбудители туберкулеза защищаются от лекарств. Если заблокировать этот механизм, бактерия начнет уничтожать себя сама. Открытие поможет создавать препараты, которые вернут эффективность существующим антибиотикам в борьбе с устойчивыми формами туберкулеза.
24 марта — Всемирный день борьбы с туберкулезом. Болезнь остается одной из главных причин смерти от инфекций: каждый день от нее умирает больше 3500 человек, а заболевает около 30 тысяч. Ситуацию усугубляет антибиотикорезистентность: бактерии уже не реагируют на самые сильные препараты и мутируют быстрее, чем создаются новые. Ученые Пермского Политеха и УрО РАН выяснили, как именно возбудители туберкулеза защищаются от лекарств. Если заблокировать этот механизм, бактерия начнет уничтожать себя сама. Открытие поможет создавать препараты, которые вернут эффективность существующим антибиотикам в борьбе с устойчивыми формами туберкулеза.
Статья опубликована в «Frontiers in Bioscience-Landmark».
24 марта — Всемирный день борьбы с туберкулезом. 144 года назад, в 1882 году, немецкий ученый Роберт Кох объявил миру, что нашел возбудителя болезни — палочку Коха. В те времена считалось, что туберкулезом болеют люди тонкой душевной организации — поэты, художники, мыслители. Об инфекционной природе болезни тогда даже не догадывались. За полтора века наука добилась впечатляющих успехов: появились вакцина БЦЖ, эффективные антибиотики, методы ранней диагностики. В России за последние десять лет заболеваемость снизилась на 53,5%, а смертность — на 67,3%.
Однако полностью победить болезнь не удалось до сих пор. Туберкулез остается одной из главных причин смерти от инфекций в мире. Ежегодно от него умирает больше 1,2 миллиона человек, а заболевает около 10,8 миллиона. По оценкам ВОЗ, инфицированы около четверти населения Земли, почти 2 миллиарда человек. Это значит, что бактерия уже есть в организме, но иммунитет ее сдерживает. Человек не болеет и не заражает окружающих. Но если защитные силы ослабевают, например, из-за стресса, плохого питания, диабета или другой болезни, инфекция может проснуться и перейти в активную форму.
Заразиться туберкулезом можно где угодно — в транспорте, магазине или офисе, если там находится больной с открытой формой. Палочка Коха передается воздушно-капельным путем и поразительно живуча: в пыли сохраняется до двух месяцев, на книжных страницах — до трех. По статистике, из 100 человек, в организм которых попала палочка, заболевают только 5-10, у остальных иммунитет не дает инфекции развиться. Реальный риск возникает при длительном и тесном общении с больным в плохо проветриваемом помещении. Кратковременные встречи на улице или в транспорте к заражению приводят крайне редко.
Главная проблема сегодня — антибиотикорезистентность, то есть устойчивость бактерий к лекарствам. Микроорганизмы мутируют быстрее, чем ученые успевают создавать новые препараты. Большинство антибиотиков находят в бактерии конкретную мишень, например, белок, который строит клеточную стенку, или фермент, копирующий ДНК, и бьют по ней. Но бактерии постоянно меняются: они могут изменить форму мишени так, что препарат перестает ее узнавать, или перенять у других бактерий гены защиты.
Уже появились формы туберкулеза, которые не чувствительны к двум самым сильным препаратам — рифампицину и изониазиду. Лечить таких больных приходится до двух лет, препараты токсичны, а эффективность падает. Ежегодно в мире регистрируют около 400 тысяч таких случаев. Бесконтрольный прием препаратов, самолечение и незавершенные курсы только усугубляют ситуацию, создавая условия для появления новых устойчивых штаммов.
Ученые Пермского Политеха и УрО РАН изучили, как микобактерии — возбудители туберкулеза — реагируют на антибиотики. В центре их внимания оказался цистеин — аминокислота, которая постоянно вырабатывается в бактериальной клетке. В нормальных условиях она нужна для роста, но под действием лекарств синтез белков останавливается, цистеин перестает расходоваться и начинает накапливаться. В больших количествах он становится ядом для самой клетки: запускает окислительные реакции, повреждающие ДНК и белки, и нарушает дыхание бактерии. Антибиотик фактически заставляет микроб производить собственное отравляющее вещество. Логично предположить, что бактерия должна погибнуть, но этого не происходит.
Чтобы разобраться, как работает этот защитный механизм, исследователи взяли безопасную для человека Mycobacterium smegmatis — близкого родственника возбудителя туберкулеза — и обработали ее двумя антибиотиками: хлорамфениколом (блокирует синтез белка) и ципрофлоксацином (повреждает ДНК), а также цистином (источником цистеина). С помощью датчиков они в реальном времени следили за дыханием бактерий, выделением сероводорода и кислотностью среды. Затем разрушили клетки и методом хроматографии определили, какие вещества в них накопились.
Чтобы разобраться, как работает этот защитный механизм, исследователи взяли безопасную для человека Mycobacterium smegmatis — близкого родственника возбудителя туберкулеза — и обработали ее двумя антибиотиками: хлорамфениколом (блокирует синтез белка) и ципрофлоксацином (повреждает ДНК), а также цистином (источником цистеина). С помощью датчиков они в реальном времени следили за дыханием бактерий, выделением сероводорода и кислотностью среды. Затем разрушили клетки и методом хроматографии определили, какие вещества в них накопились.
— В ответ на антибиотики уровень цистеина — аминокислоты, которая в избытке становится ядом для клетки — внутри бактерии резко растет. При добавлении цистина — в 3 раза, при хлорамфениколе — в 1,4 раза, при ципрофлоксацине — в 1,3 раза. Одновременно бактерия запускает защиту: избыток цистеина упаковывается в специальное вещество — микотиол. Его уровень вырос в 1,5–2 раза, причем рост цистеина и этого соединения совпадает на 95–99%. Это значит, что чем больше яда накапливается в клетке, тем активнее срабатывает защитный механизм, — рассказывает Галина Смирнова, ведущий научный сотрудник лаборатории физиологии и генетики микроорганизмов ИЭГМ УрО РАН, доктор биологических наук.
Ранее микотиол был известен тем, что защищает бактерии от внешних воздействий — антибиотиков и окислительного стресса. Оказалось, его роль шире: оно также участвует в нейтрализации внутреннего токсина, который образуется в клетке.
Цистин временно ускорил дыхание бактерий в 1,86 раза, а антибиотики замедлили его на 3–7%. Количество выделяемого сероводорода в первом случае составило 310 наномолей, во втором — всего 10–20 наномолей. Связь прямая: чем больше этого газа, тем активнее дыхание. Образующийся из цистеина сероводород работает как регулятор. В присутствии цистина он дает клетке дополнительную энергию, ускоряя метаболизм. Под действием антибиотиков его выделяется мало, и дыхание замедляется — бактерия экономит ресурсы. У микобактерий этот механизм работает иначе, чем у кишечной палочки, где сероводород в любых условиях только тормозит дыхание. Это подтверждает: для туберкулеза нужны свои, точечные решения, а не копирование стратегий, которые работают на других бактериях.
— Если заблокировать синтез микотиола, бактерия потеряет возможность прятать токсичный цистеин. Ей придется экстренно превращать его в сероводород и выбрасывать наружу. Но этот процесс требует огромных затрат энергии — клетка начнет задыхаться, утратит способность поддерживать жизненно важные процессы и в итоге погибнет от собственного яда, — объясняет Любовь Сутормина, ассистент кафедры «Химия и биотехнология» ПНИПУ.
Исследование ученых показывает: чтобы победить устойчивые формы туберкулеза, не обязательно искать новые антибиотики. Один из перспективных вариантов решения — блокировать синтез микотиола, вещества, которое позволяет бактерии прятать собственный яд. Сейчас ученые ищут молекулы, безопасные для человека, но способные отключать этот механизм. Если это удастся, даже старые препараты снова станут эффективны против штаммов, которые раньше считались неизлечимыми. Результаты работы дают основу для принципиально новой терапии — не убивающую бактерию, а заставляющую ее самоуничтожаться.
 Для справки: ранее группа ученых на примере кишечной и сенной палочек выяснила, что бактерии выживают благодаря веществу, которое собирает избыток токсичного цистеина. У кишечной палочки это глутатион, у сенной его нет, и она гибнет. Это показало: если у бактерии есть защитный буфер — она выживает, если нет — погибает от собственного яда.
Для справки: ранее группа ученых на примере кишечной и сенной палочек выяснила, что бактерии выживают благодаря веществу, которое собирает избыток токсичного цистеина. У кишечной палочки это глутатион, у сенной его нет, и она гибнет. Это показало: если у бактерии есть защитный буфер — она выживает, если нет — погибает от собственного яда.
1. выделите текст с ошибкой 2. нажмите Ctrl + Enter 3. напишите комментарий





